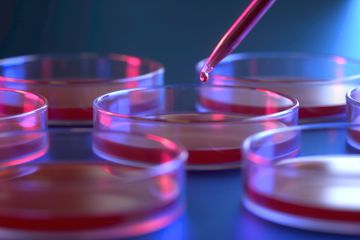

US campuses retreat from vaccine mandates despite Omicron surge
As Cornell and others close, dozens of institutions seize on court order ending federal immunisation requirement

As Cornell and others close, dozens of institutions seize on court order ending federal immunisation requirement

Warned over reliance on students from abroad, career-focused campuses hope for more government investment while chasing prospects beyond usual supplying nations

Benefits of innovative grant selection method must be balanced with risks to funders’ reputations, explain research leaders

Persuasion is everywhere, but universities could do a public service by communicating the messy, uncertain truth more widely, says Michael Blastland

Vice-chancellor commits to ‘challenging and confronting debate’ on hot-button issue
MPs investigate role of journal publication in the early stages of the pandemic

European University Association survey also highlights importance of increasing staff support and management buy-in

UK’s post-Brexit global exchange scheme could be boosted by extending student visitor visas from six months to one year, says UUK report

Outgoing director of top US research funder holds firm on China crackdown, regrets state of racial equity and keeps pondering more holistic approach

They helped create the problems we face. Now business schools should be fundamentally reimagined as democratic institutions, says Carl Rhodes

Canberra demands revamped governance and more applied focus

Institution’s director says sorry after review set up in wake of BLM movement and ‘broader concerns’ from staff and students

Kalinga Institute of Industrial Technology gets leadership prize for ‘volume and range’ of Covid-19 contributions

Students protest after staff dismissed and tenure evaluations halted at Centre for Research and Teaching in Economics

Dirk Brockmann, branded a ‘lockdown maker’ by Bild, says scientists must make clear the uncertainty in their advice